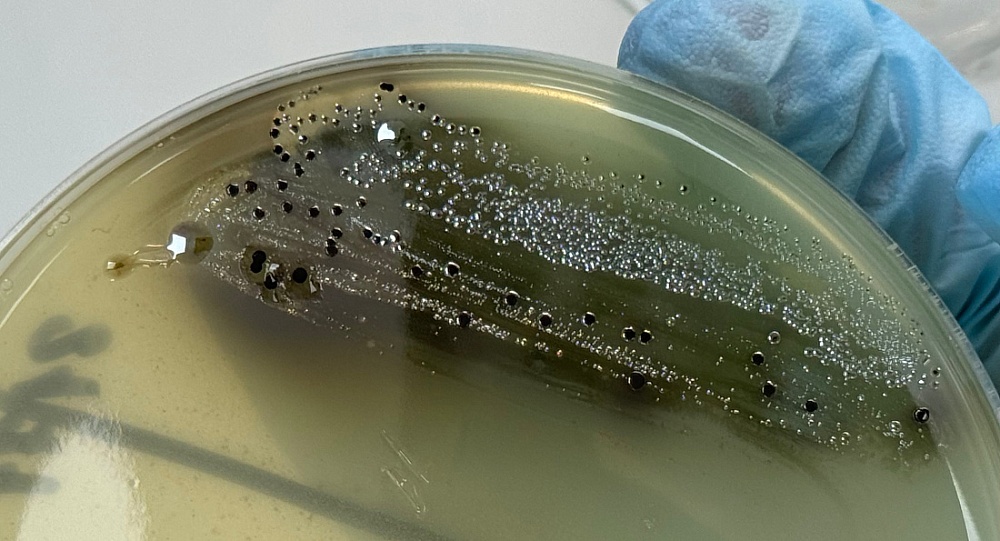
Партию курицы с сальмонеллой выявили эксперты в Астрахани

В ходе лабораторных исследований образца охлажденной курицы специалисты Астраханского филиала ФГБУ «ЦОК АПК» обнаружили бактерии рода Salmonella (сальмонеллы).
Общий вес партии составил 400 кг. Выявленные бактерии относятся к категории патогенных микроорганизмов, представляющих прямую угрозу для здоровья потребителя. Информация передана в Управление Россельхознадзора по Ростовской, Волгоградской, Астраханской областям и Республике Калмыкия.
Заражение сальмонеллой мясной продукции, как правило, происходит на этапах технологического процесса – при убое, последующей разделке тушек или хранении, если допускаются нарушения санитарно-гигиенических норм и правил.
Salmonella хорошо переносит низкие температуры и заморозку на протяжении нескольких месяцев. Гибель бактерии происходит при температуре от +60 °С в течение получаса или мгновенно – при кипячении.
Употребление в пищу мяса птицы, заражённой бактериями рода Salmonella, может привести к сальмонеллёзу – острому инфекционному заболеванию.
Фото: ЦОП АПК